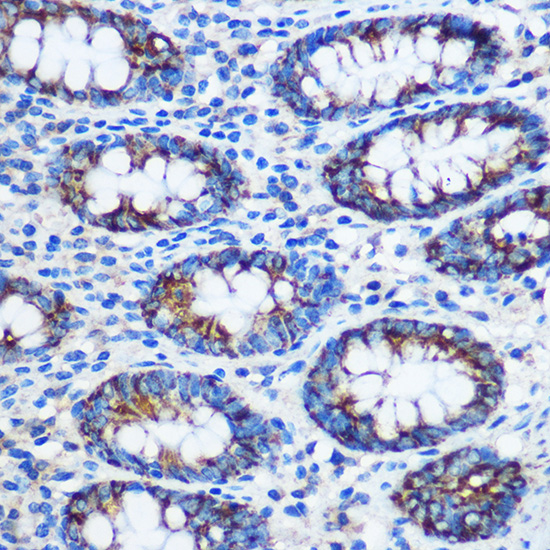

Western blot analysis of extracts of various cell lines, using TGN46/TGN46/TGOLN2 antibody at 1:1000 dilution.
Secondary antibody: HRP Goat Anti-Rabbit IgG at 1:10000 dilution.
Lysates/proteins: 25ug per lane.
Blocking buffer: 3% nonfat dry milk in TBST.
Detection: ECL Basic Kit .
Exposure time: 1min.
电话:025-68037686
地址:江苏生命科技创新园F6幢1层
订购:nanjing03@biogot.com
服务:biorase01@biogot.com
合作:lvyun@biogot.com
支持:may@biogot.com